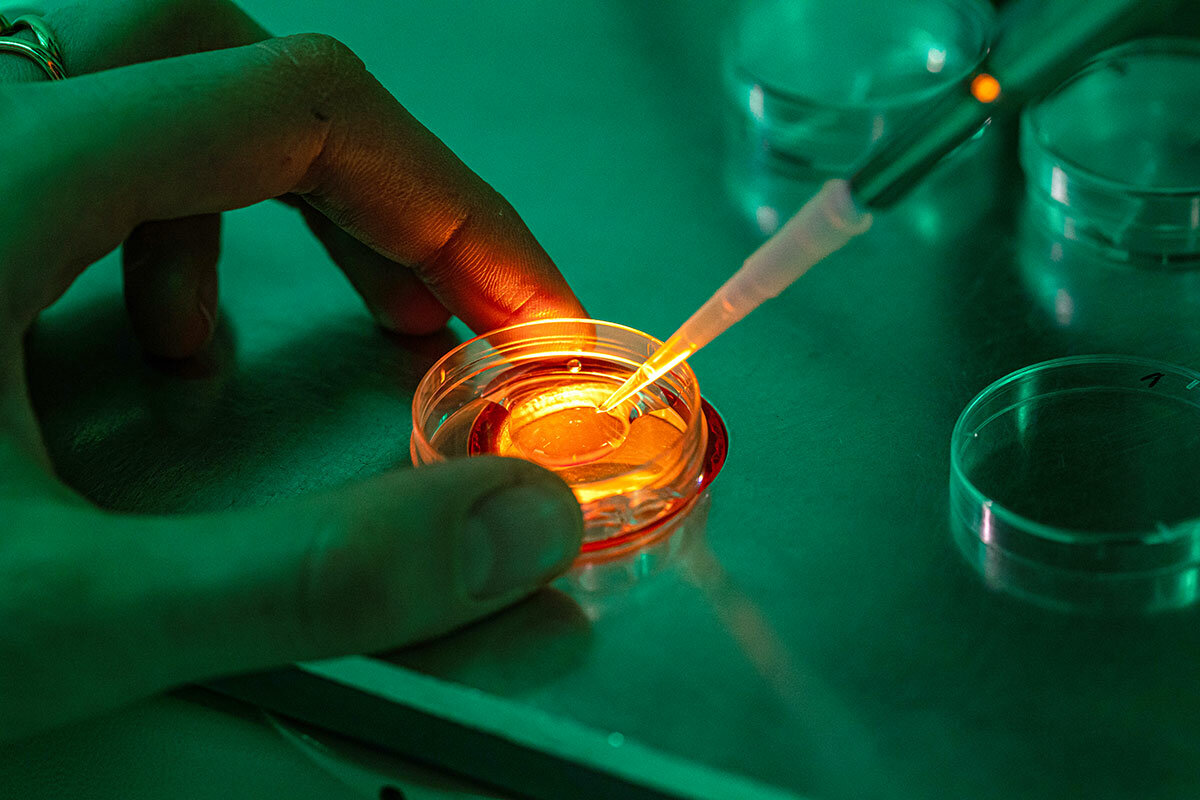

In Pictures: Inside the quest to save the northern white rhino
Loading...
The last two remaining northern white rhinos are kept behind electrified fences and protected by a squad of rangers at the Ol Pejeta Conservancy in Kenya. Up close, females Fatu and Najin seem unperturbed by the wider implications of their subspecies’ imminent extinction, a consequence of widespread poaching, habitat loss, and wars.
Their nights are spent in their snug straw-covered pens among whistling thorn trees. From about 6 to 9 a.m. they can be found grazing within their approximately 1-square-mile enclosure.
Najin and Fatu were born at the Safari Park Dvu˚r Králové, a zoo in the Czech Republic. Both are descended from the last northern white rhino male, named Sudan: Najin is his daughter, while Fatu is his granddaughter.
Why We Wrote This
Kenya’s increased protection of its overall rhino population has led to a steady increase in numbers. But for the northern white rhino, efforts beyond conservation are urgently needed.
The two of them, along with Sudan and a male named Suni, were transferred to Ol Pejeta in 2009, in the hope that returning them to their natural habitat might help them regain their zest for life and encourage reproduction.
Little went according to plan. The four imported rhinos did mate, but to no avail. In 2014, Suni died of natural causes. In 2018, Sudan, the last northern white male standing, was euthanized after a series of health problems.
Kenya has the second-largest rhino population in the world, behind South Africa. The species include the smaller black rhino and two subspecies of white rhino – northern and southern. Overall, Kenya’s approach to conservation of the animals has proved successful. For the past few years, the population of black and southern white rhinos has been slowly expanding each year. Last year, the Kenya Wildlife Service reported that not a single rhino had been killed in the country. Researchers say the improvements are due to a combination of factors, including better training of rangers, improved tracking of animals, and stricter laws that call for long prison sentences and fines of $200,000 for convicted poachers.
But conservation alone cannot save the species. Enter the scientists of the BioRescue international consortium, which is developing techniques to resurrect the northern white rhinos, including in vitro fertilization. In the laboratory of one consortium partner, the Avantea company, sperm from the deceased male, Suni, was injected into eggs from Fatu, creating 12 northern white rhino embryos. The embryos are stored at minus 196 degrees Celsius at Avantea’s facility in Cremona, Italy.
The plan is to transfer the embryos into southern white rhino surrogate mothers. “One male and one female are not enough to foster a self-sustaining population,” says Cesare Galli, Avantea’s founder and managing director. “If we create four embryos per year, that makes 16 in just four years. If we reach a 50% success rate, we will have eight new animals. With this number we aren’t exactly able to entirely repopulate Kenya, but it’s a start.”
The southern white rhinos were facing a similar situation. But after the South African government put them under special protection, their numbers soared to more than 20,000. With the help of scientists, the northern white rhinos of Kenya may yet be brought back from the brink.